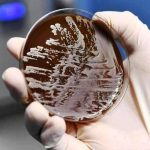

DueCi Promotion organizza un corso ecm gratuito per medici, infermieri, infermieri pediatrici e farmacisti.
DueCi Promotion è Provider ECM autorizzato dal Ministero della Salute con ID n° 1463.
Inizio iscrizioni 07-12-2020, Fine iscrizione 14-12-2021. Posti liberi 6626, accreditato il 09-09-2020. Eroga 25 Crediti ECM, ore formative 25, codice Evento 1463-305259.
Presentazione
Sempre più attuale è la necessità di assicurare una qualificata tutela della salute ad una fascia così delicata come quella dei bambini. Per questi soggetti si devono predisporre protocolli di prevenzione, di diagnosi e di terapia realizzati tenendo conto della peculiarità e della fragilità di questa fase di vita.
A questo scopo è stata progettato questo corso di formazione a distanza che approfondirà cinque aspetti della pediatria di estrema attualità.
Verranno affrontati i temi dello svezzamento e tutto ciò ad esso collegato : il cambiamento delle difese immunitarie) il cambiamento dell’umore del bebè e come cambia il suo sonno.
Verranno discusse le più corrette modalità per affrontare e sostenere i genitori nei più comuni disturbi delle vie respiratorie.
Un’ampia sezione sarà dedicata al ruolo fondamentale del sistema immunitario del bambino, e come da esso dipendano numerose allergie. Su questo tema verranno elargiti consigli terapeutici da grandi esperti per garantire un alto grado di formazione scientifica a tutti i discenti.
MODULO I : Nutrizione in età pediatrica
- L’importanza del latte materno (E. Verduci)
- Svezzamento: prevenzione e cura delle allergie ed intolleranze alimentari (E. Verduci)
- Auto svezzamento: luci e ombre (E. Verduci)
- Frutta e verdura: convenzionale, biologica o omogeneizzata (E. Verduci)
- Disturbi del sonno durante la fase dello svezzamento (E. Verduci)
MODULO II: Allergologia e Pneumologia in età pediatrica
- La rinite in età pediatrica: come riconoscerla e curarla (M. Miraglia del Giudice)
- Wheezing prescolare: dalla diagnosi alla terapia (M. Miraglia del Giudice)
- L’ Asma: linee guida e novità (M. Miraglia del Giudice)
- L’importanza della terapia di fondo dell’asma (P. Cantone)
- Immunoterapia specifica nelle allergie respiratorie (S. Barberi)
MODULO III: Malattie infettive in età pediatrica
- La febbre e dolore in età pediatrica (M. Miraglia del Giudice)
- Il ruolo della vaccinazione nelle malattie infettive (G. Bona)
- Il nuovo calendario vaccinale per la vita (G. Bona)
- La vaccinazione antimeningococcica di tipo B: luci ed ombre (G. Bona)
- Le reazioni avverse alla vaccinazione: mito e realtà (G. Bona)
MODULO IV: Gastroenterologia in età pediatrica
- Microbiota intestinale: l’organo fragile (V. Miniello)
- Approccio al bambino con disturbi funzionali gastrointestinali (V. Miniello)
- Probiotici nel neonato e nel bambino: a cosa servono? (V. Miniello)
- Probiotici e sistema immunitario: quale link? (V. Miniello)
- Trattamento e prevenzione della gastroenterite acuta (P. Garofalo)
MODULO V: Immunologia in età pediatrica
- Il sistema immunitario nei bambini ( R.Badolato)
- Allergie: spia di un sistema immunitario in disequilibrio? ( R.Badolato)
- Dermatite atopica: hanno un ruolo l’alimentazione e gli integratori? ( R.Badolato)
- Dall’allattamento al divezzamento: come cambiano le difese immunitarie nel bambino ( R.Badolato)
- II modificatori della reattività biologica: Focus on Pidotimod (P. Marchisio)
Obiettivo formativo
3 – Documentazione clinica. Percorsi clinico-assistenziali diagnostici e riabilitativi, profili di assistenza – profili di cura
Mezzi tecnologici necessari
I requisiti necessari per fruire dell’evento FAD sono semplici:
- Pc con sistema operativo Windows (windows 10 o superiore)
- Mac (OS 10 o superiore)
- Dispositivi Mobile (per la fruizione dei corsi se realizzati con tecnologia compatibile)
- I più recenti browser web aggiornati (es.: Chrome, Firefox, Edge)
- Connessione Internet
- Amplificatore audio con altoparlanti (per la fruizione dei corsi con contributi audio)
N.B.: È consigliato utilizzare browser web aggiornati all’ultima versione.
Procedure di valutazione
Questionario on-line a risposta multipla con doppia randomizzazione.
Per conseguire i crediti ECM relativi all’evento è obbligatorio: rispondere correttamente ad almeno il 75% dei quesiti del questionario di apprendimento (sono consentiti al massimo cinque tentativi di superamento della prova, previa la ripetizione della fruizione dei contenuti per ogni singolo tentativo), compilare la scheda di valutazione evento FAD e il questionario di qualità.
Per potersi iscrivere cliccare sul seguente link
https://fadueci.com/event/58/subscribe
Redazione Nurse Times
Ultimi articoli pubblicati
- Schillaci difende la riforma, ma esplode il caso Enpam: scontro sulla medicina territoriale
- Asl Salerno paga gli infermieri 40 euro l’ora: i medici chiedono di fermare il bando “sono troppi”
- Sanità Puglia, Decaro rassicura: concorsi OSS, assunzioni e stabilizzazioni avanti senza stop
- Riforma dei medici di famiglia, stop della maggioranza: rischio per le Case della Comunità
- Pisa, intervento eccezionale su paziente con colangiocarcinoma giudicato inoperabile

Lascia un commento